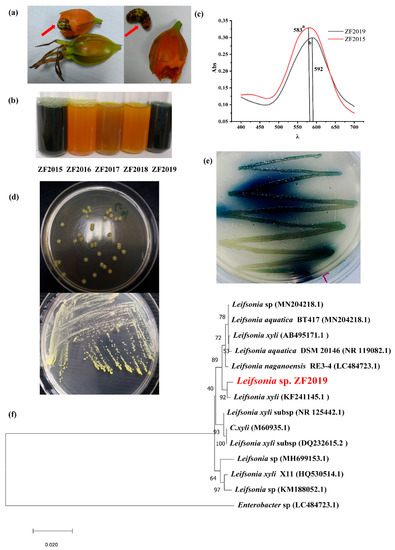

Abstract
To produce gardenia blue pigment (GBP) by natural fermentation, a novel bacteria, Leifsonia sp. ZF2019, was isolated from the larvae of a pest of Gardenia jasminoides Ellis fruits and shown to be able to convert gardenia yellow waste production (GYWP) into GBP. The fermentation medium and growth conditions were screened, and the GBP yield, color value, and stability were compared to those of Aspergillus niger fermentation. Leifsonia sp. ZF2019 was shown to effectively produce GBP in medium containing GYWP and leucine (Leu). A temperature of 35 °C, 0.8% leu content, a fermentation period of 72 h, and a pH value of 7.0 were shown to be optimal culture conditions. GBP produced by Leifsonia sp. ZF2019 was of higher yield and quality than that produced by Aspergillus niger fermentation. GBP was purified by D4020 macroporous adsorbent resin, and the effects of pH, temperature, light, oxidant and reductant, conventional food additives, and metal ions on its stability were evaluated. GBP produced by Leifsonia sp. ZF2019 fermentation was as stable as GBP generated directly by pure genipin. LC-MS revealed that the molecular formula of GBP was C37H45N2O8. Our results provide a reference for the preparation of efficient, stable, reliable, and high-quality gardenia blue pigments.
1. Introduction
Color is one of the most important sensory attributes of foods and can render the appearance of food pleasing and attractive to customers. Food colorants are extensively used in the food industry to compensate for the loss of color during food processing, storage, and packing [1,2]. Synthetic pigments have some advantages, such as high tinting strength, chemical stability, and low cost, and are primarily employed in the food and beverage industries [2]. However, there is growing concern about the adverse health effects of synthetic food colorants, especially their association with hyperactive behavior in children. In addition, growing consumer desire for sustainable, healthy, and “natural” products has rekindled an interest in natural food coloring [3].
Natural red, yellow, or orange pigments found in plants, such as carotenoids, anthocyanins, and betalains, have partially replaced synthetic colorants in the food industry [4]. Blue pigments are rare in nature, and few natural blue food colorants can replace artificial dyes, such as Blue no. 1 and Blue no. 2 [5,6]. In contrast, blue pigments are not uncommon. Phycocyanin from Spirulina spp. and some anthocyanins are employed as food-grade pigments with blue color [7,8]. However, natural blue pigments are unstable in response to heat, light, and acid, limiting their use in the food sector [7]. As an important primary colors, the lack of natural blue pigment limits the development of foods with different colors [6]. Therefore, searching for new natural blue pigments with favorable chemical stability and color hues and intensities comparable to synthetic blue pigment has attracted widespread attention [7].
Geniposide, the principal iridoid glucoside, can be transformed into genipin by β-glucosidase, which can spontaneously react with primary amine-containing compounds (such as amino acids or peptides) to produce blue pigments [6,9,10]. Geniposide is abundant in the fruits of gardenia (Gardenia jasminoides J. Ellis) and genipap (Genipa americana L.), both of which are essential sources of iridoid-based blue pigment [11]. Iridoid-based blue pigment showed suitable stability in response to pH, temperature, and light [11,12]. Paik et al. [6] transformed genipin from gardenia fruits (Gardenia jasminoides J. Ellis) to gardenia blue pigments by reaction with glycine, lysine, or phenylalanine. They discovered that the blue pigments were stable after 10 h at temperatures of 60–90 °C and under light irradiation of 5000–20,000 lux and were more stable at alkaline pH than at neutral or acidic pH. The color hue of Jagua blue (iridoid-based blue pigment derived from the fruit of Genipa americana L.) was comparable with that of Blue no. 2 at pH values of 3.6–5.0, and it was significantly more stable than Blue no. 2 under storage conditions, in addition to being less susceptible to an acidic pH of 3.6 and light than Spirulina [13]. Iridoid-based blue pigment has been reported as a safe food colorant [12,14] and has shown possible biological activity [9,10,13]. Gardenia blue pigment derived from genipin and tyrosine was recently reported to exhibit antidepressant-like activity [15]. Iridoid-based blue pigment has been identified as a promising natural color for the food industry.
Gardenia (Gardenia jasminoides) is an evergreen shrub native to East Asia and belongs to the Rubiaceae family. For thousands of years, its fruit has been utilized in traditional Chinese medicine and as a colorant [16]. The water-soluble carotenoid fraction of gardenia yellow comprises mainly crocetin and crocin and has been widely used in East Asian food, as well as the cosmetics and textile sectors [17]. The extraction of gardenia yellow pigments produces a considerable volume of byproducts with a high concentration of geniposide. Therefore, gardenia yellow extraction waste is a valuable resource for the production of iridoid-based blue pigment. Gardenia blue is typically manufactured in two steps: geniposide is biotransformed to genipin by β-glucosidase or microbe fermentation, which then interacts with amino acids to produce gardenia blue [18]. Beta-glucosidase from various microbes, including Penicillium nigricans and Trichoderma reesei [19], has been used in genipin transformation. Microbial fermentation is a low-cost and environmentally friendly way to produce gardenia blue. However, due to its low purity and color value and high cost for purification, the production of gardenia blue by fermentation is limited.
Here, a bacterium designated as ZF2019 was isolated from the gut of Artipe eryx larvae, a pest that damages the fruit of Gardenia jasminoides Ellis. The fermentation conditions for preparing GBP from GYWP by ZF2019 were optimized. In addition, the effects of physical factors (including temperature and light) and chemical factors (pH, metal ions, oxidant and reductant, glucose, and sodium bicarbonate) on the stability of the prepared GBP were analyzed. Finally, the molecular composition of GBP was analyzed.
2. Materials and Methods
2.1. Materials and Chemicals
Gardenia yellow spray dried powder (Geniposide ≥ 50%) was provided by Zhejiang Suichang Liming Pharmaceutical Co., Ltd. (Suichang, Zhejiang, China). Amino acids (Lys, Gly, Leu, Arg, Glu, His, Ser, and monosodium glutamate; ≥98%) were purchased from Sigma-Aldrich (Shanghai, China). Macroporous adsorbent resin and geniposide (≥98%), as well as genipin (≥98%) standard reagents, were purchased from Shanghai Yuanye Biotechnology Co., Ltd. (Shanghai, China). All other chemical reagents were purchased from National Medicine Group Chemical Reagent Co., Ltd. (Shanghai, China).
2.2. Bacteria Isolation and Identification
The larvae of Artipe eryx, a pest of Gardenia jasminoides Ellis that damages fruits with larvae, were collected from the campus of Zhejiang A&F University (Hangzhou, China). The larvae were immersed in 75% alcohol for 2 min before being rinsed twice with sterile water. Larvae intestines were homogenized (FA25, FLUKO, Shanghai, China) at 180 rpm with 9 mL sterilized water. Following repeated dilutions, 0.1 mL of the mixture was distributed over Luria–Bertani (LB) agar. Plates were incubated at 30 °C for 3–5 days before colonies with distinct morphologic traits were chosen. For 48 h, the strains were cultured in LB broth (containing 0.3% GYWP) at 30 °C in a shaking incubator (180 rpm). The maximum absorbance of the fermentation broth was evaluated using a UV-visible spectrophotometer (Persee Analytics, Beijing, China) between 400 and 700 nm to screen gardenia blue product (GBP) bacteria. A blue pigment with a maximum absorption peak of more than 590 nm is generally defined as a promising GBP [20]. Based on the maximum absorption peak of fermentation broth, a bacterium strain designated as ZF2019 was selected for further fermentation experiments.
The genomic DNA of ZF2019 was extracted with a DNA extraction kit (Tiangen, Beijing, China) according to the manufacturer’s instructions. The 16S rDNA sequence was amplified using universal primers (27F-5′-AGAGTTTGATCCTGGCTCAG-3′, 1492R: 5′-TACGGCTACCTTGTTACGACTT-3′). The amplified product was sequenced and blasted against the NCBI GenBank database using the BLASTn program. Multiple sequence alignment was conducted using Clustal-X, and phylogenetic analysis was performed using MEGA-X 5.0 software (version 5.0, Mega Limited, Auckland, New Zealand). A molecular phylogenetic tree was constructed by the neighbor-joining method, and the self-development test bootstrap values repeatedly obtained 1000 times were marked on the branches to evaluate the confidence of the phylogenetic tree.
2.3. HPLC Analysis
HPLC was carried out on an Essentia LC-16 liquid chromatography system (Shimadzu, Suzhou, China) equipped with a 600E liquid delivery system, an SIL-16 automatic injector, and an SIL-16 UV detector. Geniposide and genipin analysis was performed on and UItimate XB-C18 column (4.6 × 250.0 mm, Welch Materials Inc, Shanghai, China). Compounds were separated from the column using a gradient elution program of acetonitrile (phase A) and water (phase B) as mobile phase (10% A for 0 min; 10–18% A for 0–5 min; 18–38% A for 5–8 min; 38% for 8–12 min; 38–10% A for 12–13 min; 10% A for 13–20 min) with a flow rate of 1.0 mL/min at 35 °C and detected by absorbance at 238 nm. The geniposide and genipin contents were calculated according to the calibration curve of the standards (peak area concentration).
2.4. Effect of Carbon or Nitrogen Resources, Leu Concentrations, pH, and Incubation Times on the Gardenia Blue Yield and the Rates of Geniposide Transformation to Genipin
Leifsonia sp. ZF2019 was cultivated overnight in LB broth at 37 °C with shaking (180 rpm, 12 h). Then, 4 mL of culture was transferred to 100 mL of various fermentations in 250 mL Erlenmeyer flasks and incubated at 37 °C in a shaking incubator (180 rpm, 72 h).
An initial medium (0.75% GYWP, 1% KH2PO4, 0.3% Leu, 2% glucose, and initial pH = 7.0) was selected for Leifsonia sp. ZF2019 fermentation. To assess the effect of amino acids on the GBP product, Leu was replaced with Lys, Gly, Arg, Glu, MSN, or Ser, and the maximum absorption peak and absorbance were compared. To screen carbon resources, sucrose, fructose, cellulose, or lactose was used instead of glucose. To assess the effect of nitrogen resources on the geniposide conversion rate, 0.3% Leu, 0.3% yeast extract, 0.3% tryptone, 0.3% Leu + 0.3% (NH4)2SO4, or 0.3% Leu + 0.3% Na2NO3 were utilized as nitrogen resources, and the geniposide conversion rate was compared. Leu concentrations (0.3%, 0.4%, 0.5%, 0.6%, 0.7%, and 0.8%) and pH (6.0, 7.0, 8.0, 9.0, and 10.0) were also screened. The fermentation media were sterilized at 121 °C for 20 min before inoculation. After 72 h of fermentation, the gardenia blue yield and genipin transformation rate were examined by measuring the 592 nm (Persee Analytics, Beijing, China) absorbance and HPLC analysis, respectively.
To investigate the influence of fermentation time on the gardenia blue yield and genipin transformation rate, Leifsonia sp. ZF2019 were grown in the fermentation media (0.75% GYWP, 1% KH2PO4, 0.7% Leu, and pH = 7.0) at 37 °C with shaking (180 rpm). Every 12 h, 4 mL of culture was withdrawn, and the 592 nm absorbance and geniposide contents were measured. The geniposide conversion rate was expressed by the following formula:
Geniposide conversion rate (%) = (initial content of geniposide − amount of residual geniposide)/content of initial addition of geniposide × 100%
2.5. GBP Preparation
To prepare GBP, Leifsonia sp. ZF2019 was grown in fermentation medium (0.75% GYWP, 1% KH2PO4, 0.7% Leu, and pH = 7.0) at 37 °C with shaking (180 rpm). After 72 h of incubation, the fermentation broth was centrifuged (10,000 rpm) at 4 °C for 20 min. The supernatant was filtered with 0.22 μm membrane and stored at −20 °C for further analysis.
2.6. Screening of Macroporous Adsorbent Resins for GBP Purification
Eleven types of macroporous resins (HPD100, D4020, NKA-9, DM130, D101, HPD722, HPD450, S-8, XAD1180, AB-8, and D113) were selected for GBP purification. Each macroporous resin was successively pretreated with 95% alcohol, 5% NaOH, 5% HCl, and distilled water in sequence. These pretreated resins (3 g) were mixed with the diluted GBP fermentation broth (30 mL) (Ab592 = 0.820). After 24 h at room temperature, the 592 nm absorbance of the supernatant was measured, and its adsorption rate was calculated. To evaluate the GBP desorption rate, the resin was rinsed with deionized water until it was colorless and transparent. Then, the GBP was eluted with 10 mL of 100% ethanol three times. The eluted GBPs were mixed, and the absorbance was measured. The adsorption and desorption rates were computed as follows:
where A0 is the absorbance of the GBP solution before adsorption, A1 is the concentration of the GBP solution after adsorption, and A2 is the absorbance of the supernatant after desorption by adsorbed resin.
Adsorption rate (%) = (A0 − A1)/A0 × 100%
Desorption rate (%) = (A2 − A1)/A0 × 100%
2.7. GBP Purification with Macroporous Adsorbent Resins
GBP fermentation broth (Ab592 = 0.820) was mixed with selected macroporous resins at a rate of 100 mL/10 g resin. After extensive washing with distilled water, the GBP was eluted with 100% ethanol three times [21]. Ethanol was removed by vacuum rotary evaporation at 40 °C. GBP was dissolved with distilled water, freeze-dried, and stored at 4 °C.
2.8. Comparison of the Yield and Quality of GBP Produced by Leifsonia sp. ZF2019 and Aspergillus niger
Leifsonia sp. ZF2019 and Aspergillus niger ACCC30176 (Agricultural Culture Collection of China, Beijing, China) were cultured in fermentation media (0.75% GYWP, 1% KH2PO4, 0.7% Leu, and pH = 7.0) with shaking (180 rpm). The fermentation temperature and time of ZF2019 and Aspergillus niger were 37 °C for 72 h and 28 °C for 120 h, respectively. After centrifugation and filtration, the fermentation broth was divided into two parts. One was directly freeze-dried (unpurified sample), and the other was purified with macroporous resin as described in Section 2.6 and freeze-dried (purified sample). Finally, the GBP yield was calculated.
The color value of the GBP was measured by a UV-visible spectrophotometer (Persee Analytics, Beijing, China). Briefly, the purified pigment sample (0.1 g) was dissolved in 50 mL of deionized water and measured at 592 nm. The color value was calculated using the following equation:
where A is the sample absorbance, c is the sample concentration (g/mL), and E is the color value of the pigment (1% sample concentration, 1 cm cuvette). The hue of the GBP was measured by a CM-700d colorimeter (Konica Minolta, Tokyo, Japan). Briefly, GBPs were diluted with distilled water to an absorbance value of A592 = 0.5 and were observed by a 1 × 10−3 m measuring aperture and a 5 mL cuvette (1 cm path length) equipped with a D65 light source and an observation angle of 10°. Reflectance-specular included (RSIN) mode, which measures total reflectance, including diffuse reflectance and specular reflectance, was used. The L, a, and b values were recorded. “L” is lightness/darkness, “a” is red/green, and “b” is yellow/blue, with negative values indicating red or yellow, respectively.
E1%1cm (592 nm) = A/(100 × c)
2.9. Effects of pH, Temperature, Light, and Additive Type on the Stability of GBP
The pH value of purified GBP solution (Ab592 = 0.817) (pH = 3, 5, 7, and 8.5) was adjusted by citric acid buffer solution (0.1 mol/L) and disodium hydrogen phosphate solution (0.2 mol/L). After 24 h in the dark, the UV absorption wavelength was scanned with a UV-visible spectrophotometer in the range of 400–700 nm.
The GBP solution with varying pH values was prepared and heated to 60 °C, 80 °C, and 100 °C for 2 h. After an ice bath, the absorbance was measured at 592 nm to calculate the retention rate of GBP according to the following formula:
where Abs (tn) represents the absorbance value of the GBP solution after standing for t h, and Abs (t0) represents the initial absorbance value of the GBP solution.
Retention rate (%) = Abs (tn)/Abs (t0) × 100%
The GBP solution with varying pH values was prepared and exposed to a 12,000 lux lightbox for 12 h, and the absorbance was measured at 592 nm to calculate the retention rate according to Formula (4). Similarly, the GBP solution (pH = 7) with varying concentrations (1.25%, 2.5%, and 5%) of oxidants and reductants (K2Cr2O7, Na2SO3, and Vc) was prepared left to stand for 2 h, 4 h, 7 h, 11 h, and 24 h in the same environment; the GBP solution (pH = 7.0) with varying concentrations (0.1%, 1%, and 2%) of glucose and NaHCO3 was prepared and stored for 2 h, 7 h, 19 h, 30 h, and 42 h in the same environment; the GBP solution (pH = 7.0) with 5 mmol/mL of various metal ions (Al3+, Ca2+, Fe3+, Fe2+, K+, Mg2+, Cu2+, and Na+) was prepared and allowed to stand for 0.5 h, 1 h, 2 h, 4 h, and 6 h in the same environment. The retention rates of the GBP solutions were calculated according to Formula (4).
2.10. LC-MS Analysis
LC-MS analysis was performed in full accordance with the procedures as previously described with UPLC-qTOF-MS (AB5500, Agilent, Santa Clara, CA, USA) [12]. In short, GBP powder (10 mg) was dissolved in 0.5 mL of methanol and filtered through a 0.22-μm filter membrane as a test solution. These fractions were analyzed in positive ion mode using an HPLC (Hewlett Packard, Agilent Technologies 1290 series, Santa Clara, CA, USA) coupled with a Waters BEH C18 120 SB-Aq 2.7 μm reversed phase column (2.1 × 50 mm, 1.7 μm, Agilent, Santa Clara, CA, USA) and a Q-ToF iFunnel 6550 mass spectrometer fitted with an electrospray ionization (ESI) source. Mobile phase A consisted of a 0.1% (v/v) solution of formic acid in water, and mobile phase B was methanol. The samples were eluted with a flow rate of 0.3 mL/min following linear gradients (v/v) of mobile phases: 0–1 min, 10% B; 1–0 min, 10% B to 90% B; 9–12 min 90% B; 12–12.1 min, 90% B to 10% B; 12.1–13 min, 10% B. The mass spectrometer parameters were as follows: VCap 4000 V; sheath gas temperature, 350 °C; drying gas, 12 L/min. The mass spectra acquisition range was 50–1000 m/z.
2.11. Statistical Analysis
All data are presented as mean ± SD. Differential analysis was performed by t-test using SPSS, version 20.0 (IBM Corp., Armonk, NY, USA), and p < 0.05 was considered statistically significant.
3. Results and Discussion
3.1. Leifsonia sp. ZF2019 Strain Isolation and Identification
The larvae of Artipe Eryx, a Lepidoptera pest, can feed on gardenia fruit (Figure 1a). As geniposide is the main component of gardenia fruit, we speculated that some bacteria in its gut might assist Artipe Eryx larvae in hydrolyzing geniposide. Here, the gut bacteria were isolated, and five of them (designated as ZF2015-ZF2019) were selected according to the morphological characteristics of the colonies to evaluate their GBP product capability. Among them, strains ZF2015 and ZF2019 produced GBP in LB broth (containing 0.3% GYWP) within 24 h (Figure 1b). The maximum absorption peak for strains ZF2019 and ZF2015 was 593 nm and 582 nm, respectively (Figure 1c). GBP with a maximum absorption peak of more than 590 nm is generally defined as a qualified product [20]. The results suggest that strain ZF2019 is a potential bacterium to produce GBP. Strain ZF2019 was selected for further examination. The morphological analysis results (Figure 1d) show that the colonies of ZF2019 cultured at 35 °C for 24 h in LB were round; the overall color was yellow; and the colonies were moist, sticky, and easy to sample. In addition, further solid fermentation culture showed that strain ZF2019 utilized GYWP to produce GBP (Figure 1e).
Figure 1.
(a) Larvae of Artipe Eryx born inside gardenia fruits, leading to an empty fruit (nearly 30–40% empty fruit rate). (b) Color observation of GBP fermented by five strains from the larvae of Artipe Eryx, including ZF2015~2019 in LB liquid medium. (c) UV spectra of GBP fermented by ZF2015 and ZF2019. (d) Morphological observation of strain ZF2019. Different letters represent different maximum absorption wavelengths. (e) Observation after GBP production by strain ZF2019 on an agar plate. (f) Phylogenetic tree of Leifsonia sp. ZF2019 and corresponding strains based on 16S rRNA analysis. The phylogenetic tree was constructed by the neighbor-joining method, and the bootstrap value of the self-expanding test was marked on the branches 1000 times to evaluate the confidence of the phylogenetic tree and to determine the phylogenetic relationship and taxonomic status of the strains.
To identify strain ZF2019, 16S rDNA was amplified by PCR, and its complete sequence was analyzed and compared by BLAST [22]; furthermore, the phylogenetic tree was constructed by the neighbor-binding method (Figure 1e). The 16S rDNA complete sequence of ZF2019 showed 97% homology with Leifsonia xyli (KF241145.1). Generally, a similarity of 16S rDNA genes less than 98.7% was proposed as the cutoff for species; thus, ZF2019 might be a new species in the Leifsonia genus and was therefore named Leifsonia sp. ZF2019. The Leifsonia genus was first discovered in 1962 and belongs to the Microbacteriaceae family; its type species is Leifsonia aquatica (ex Leifson 1962) [23]. To date, 19 species have been discovered in the Leifsonia genus. The subspecies of Leifsonia xyli are mainly derived from soil. Few reports have been published on the biological functions of this type of subspecies, and only limited reports indicate that its subspecies could asymmetrically reduce 3,5-bis (trifluoromethyl) acetophenone to (1R)-[3,5-bis(trifluoromethyl) phenyl] ethanol [24,25]. We found that Leifsonia sp. ZF2019 could produce blue pigment using gardenia yellow wastewater as the raw material.
3.2. Influences of Amino Acid Type, C, and N Resources on the GBP Product by Leifsonia sp. ZF2019
Generally, genipin can react with amino acids to produce blue pigments. Thus, the type and content of amino acids can affect the color distribution and yield of the formed blue pigment. In our current study, strain ZF2019 was found to produce β-glucosidase, which was able to catalyze and convert geniposide to genipin. Additionally, it has been reported that GYWP contains a large amount of geniposide [21]. Therefore, fermentation of GYWP by strain ZF2019 is a feasible and practical method for producing GBP. As shown in Figure 2a, GBP fermentation with Leu resulted in a bright blue color, with a maximum absorption wavelength of 592 nm and absorbance of 0.319, indicating that Leu was an ideal amino acid for Leifsonia sp. ZF2019 to produce GBP. It is well-known that the amino acid metabolism of bacteria is strictly regulated, and the addition of amino acids may affect bacterial amino acid metabolism, thus affecting growth [21]. Although further experiments are required to confirm this phenomenon, it may explain why Leu is a better amino acid for producing GBP.

Figure 2.
(a) Categories of amino acids affected the λmax, Abs, and color of GBP in the spectrophotometric study. λmax, maximum absorption wavelength of GBP; Abs, absorbance value of gardenia blue pigment at maximum absorption wavelength. Different C sources (b) and N sources (c), Leu content (d), medium pH (e), and reaction times (f) affected the geniposide conversion rate and GBP maximum absorption (yield). MSG, sodium glutamate; ns, not significant.
In addition to the type of amino acids, C and N sources are also critical factors that cannot be ignored during the fermentation of strain ZF2019 to produce GBP. Figure 2b shows the effect of the C source on the conversion rate of geniposide and GBP yield (expressed by the absorbance at A592) in medium. Interestingly, adding fructose, glucose, lactose, cellulose, or sucrose led to a decrease in the conversion rate of geniposide or the GBP yield, which is probably ascribed to the inability of these saccharides to induce β-glucosidase expression in bacteria. Organic N sources (including yeast extract, urea, and tryptone) also decreased the conversion rate of geniposide and the GBP yield; NaNO3 did not significantly affect the conversion rate of geniposide or the GBP yield, whereas (NH4)2SO4 elevated the conversion rate of geniposide but reduced the GBP yield (Figure 2c). Consistent with the results reported by Xu et al. [26], our results showed that high-geniposide conversion and GBP could be yielded without additional C and N sources in the medium. The cost of the culture medium is a critical factor in determining the feasibility of the fermentation process. Because no other nutrients were added to the current fermentation medium, production is expected to be cost-effective [26].
3.3. Antioxidant and Hepatoprotective Activity and the Influence of Leu Concentration, pH, and Fermentation Time on the GBP Produced by Leifsonia sp. ZF2019
To further obtain a high geniposide conversion rate and GBP yield, leucine content, fermentation pH, and fermentation time were also studied. As shown in Figure 2d, the conversion rate of geniposide and GBP yield increased in a Leu-concentration-dependent manner (0.3–0.8%). The conversion rate of geniposide reached 97.7 ± 0.9%, and the A592 absorbance of GBP was 0.89 ± 0.02 at 0.8% leucine concentration.
The initial pH affects the growth rate of the bacteria and the utilization rate of nutrients, thereby affecting the production of GBP and the conversion rate of geniposide [7]. For example, the influence of pH is shown in Figure 2e; the maximum conversion rate of geniposide (85.40 ± 0.73%) occurred at pH = 7.0, suggesting that 7.0 was the optimum pH for the growth and secretion of glucosidase of Leifsonia sp. ZF2019.
Fermentation time is an essential factor affecting the quality of GBP. Poor fermentation results in a low geniposide conversion rate, low production, and green color of GBP, whereas overfermentation results in lower quality and purple color of GBP [21]. The conversion rate of geniposide and GBP yield initially increased in association with fermentation time, but the geniposide conversion rate and the A592 value became stable when the fermentation time exceeded 72 h (Figure 2f).
According to our data, the conversion rate of geniposide can reach 98.96 ± 0.06% under optimized conditions (0.8% leucine, pH = 7.0, and 72 h for fermentation time).
3.4. GBP Purification by Macroporous Adsorption Resins
Eleven types of macroporous adsorption resins were employed to screen the macroporous resins for Leu-based GBP purification. As illustrated in Table S1, D4020 demonstrated the highest adsorption rate for GBP, followed by HPD450, NKA-9, XAD1180, and DM130. D4020, HPD450, NKA-9, XAD1180, and DM130 5 resins were further evaluated, and D4020 and HPD450 resin showed the highest desorption rates. D4020 was selected as the resin for GBP purification resin based on the combined results of adsorption and desorption rates.
3.5. Comparison of GBP Fermentation by Leifsonia sp. ZF2019 and Aspergillus niger
Aspergillus niger and its secondary metabolic enzymes are usually used to investigate the production and synthesis of pigments [27,28]. Therefore, we compared the yield and color scale of GBP produced by Aspergillus niger and that produced by Leifsonia sp. ZF2019 fermentation. More than 20.7 g/L crude GBP and 4.3 g/L purified GBP were obtained from Leifsonia sp. ZF2019 fermentation, whereas the amount of crude GBP and purified GBP obtained from Aspergillus niger fermentation was 14.5 g/L and 1.95 g/L, respectively (Figure 3a). The crude GBP color values of Leifsonia sp. ZF2019 and Aspergillus niger were 49 and 38, respectively. The GBP color value was improved by macroporous resin purification, reaching 188 (Leifsonia sp. ZF2019) and 128 (Aspergillus niger) (Figure 3b). The results reveal the excellent GBP production capability of Leifsonia sp. ZF2019.

Figure 3.
The color scale (a) and yield (b) of Leifsonia sp. ZF2019 and Aspergillus niger differed significantly before and after purification. Three GBPs from distinct sources differed in terms of lab color model, including L (c), a (d), and b (e) values. In the figure, 1 represents the GBP prepared by Leifsonia sp. ZF2019 fermentation, 2 is the GBP fermented by Aspergillus niger, and 3 represents the GBP obtained by the reaction of genipin (≥98%) with Leu. The asterisk represents a significant difference between the groups. *, p < 0.05; **, p < 0.01; ***, p < 0.001; ns, not significant.
To evaluate the quality of the GBP, the hue of purified GBP produced by fermentation of Leifsonia sp. ZF2019 and Aspergillus niger were measured using a colorimeter, and the GBP that was directly produced by genipin and Leu was used as the control. As shown in Figure 3c–e, there was no significant difference in the color intensity (L, a, and b values) between GBP produced by Leifsonia sp. ZF2019 and that produced by Aspergillus niger. However, the color intensity of GBP produced by fermentation was slightly lower than that of produced by genipin and Leu. The results reveal the excellent GBP production capability of Leifsonia sp. ZF2019. Due to the high level of impurities in the fermentation broth, the color value and hue of the GBP produced by fermentation are low. GBP is usually directly synthesized from the pure geniposide or genipin. Herein, the color of GBP produced by Leifsonia sp. ZF2019 and Aspergillus niger was comparable to the product synthesized from pure genipin. Therefore, fermentation may be used as an alternative method for GBP production.
3.6. Effects of pH, Temperature, and Light on GBP Physical Stability
The blue pigment formed by pure genipin was reported to be stable for treatment at temperatures of 60–90 °C for as long as 10 h and under light irradiance of 5000–20,000 lux. It was more stable under alkaline than neutral and acidic conditions [6]. However, the components of GBP produced by the waste of GYWP are more complex than synthetic products. Whether trace amounts of iridoid compounds other than genipin, crocitin, and flavonoids can change the physicochemical stability of GBP remained to be clarified. Therefore, the influence of pH, heat, light, oxidant or reluctant, some common food additives, and metal ions on GBP stability was re-evaluated.
The effects of pH on GBP stability produced by fermentation are shown in Figure 4. The wavelength of the maximum absorption peak of GBP was not affected by the pH, but the corresponding absorbance value declined with decreased pH (Figure 4a). The effects of varied pH on the stability of GBP at temperatures of 60 °C, 80 °C, and 100 °C and 20,000 lux light intensity were further studied. At 60 °C, the color values were stable at pH = 5.0, pH = 7.0, and pH = 8.5 within 10 h, whereas the color values decreased in a time-dependent manner (Figure 4b). The color values decreased as the temperature increased (Figure 4b,c,d). Nevertheless, the color value retention rate was still higher than 80% at pH = 5.0, pH = 7.0, and pH = 8.5 within 10 h when the temperature reached 100 °C, indicating good stability. In contrast, its stability at pH = 3.0 was significantly lower than at pH values above 5.0. The influence of light irradiance on GBP stability is shown in Figure 4e,f. Although GBP stability was partially impaired by light, it retained more than 80% of the color values after exposure to 20,000 lux light for 72 h at pH values above 5.0. In addition, the color value retention rate of GBP dropped sharply at pH = 3.0 for all treatments, indicating that it might not be suitable for acidic conditions. Genipin was previously reported to be able to undergo ring-opening polymerization or self-reaction to form genipinic acid under acidic conditions [29], which may explain why GBP is sensitive to low pH values. As previously reported [6], our result also showed that high temperature and light intensity impaired the stability of GBP produced by fermentation.

Figure 4.
(a) The maximum absorbance of GBP reduced with decreased pH; the retention rate of GBP reduced with the reduction in pH at 60 °C (b), 80 °C (c), 100 °C (d), 0 lux (e), and 20,000 lux (f).
3.7. Effects of Different Types of Additives on GBP Physical Stability
The impact of oxidant or reductant on GBP stability is shown in Figure 5a,d. Although GBP was very stable with a low concentration (1.25 μg/L) of oxidant (K2Cr2O7) and reductant (Na2SO3, and Vc), there was a decreasing trend in the color value retention rate correlated with an increase in the concentration of oxidant or reductant. The effect of potassium dichromate on the retention rate of GBP outweighed that of reductants, including sodium sulfite and Vc, which can be partly explained by their degradation resulting from oxidation [30]. However, the color value retention rate remained over 70% for 24 h.

Figure 5.
(a) Varying concentrations of oxidant and reductant decreased the retention rate of GBP. (b) Varying concentrations of glucose and sodium bicarbonate reduced the retention rate of GBP. (c) The coexistence of various metal ions reduced the retention rate of GBP. (d) Schematic diagram of GBP degradation.
As conventional food additives, glucose and sodium bicarbonate are widely used in beverages and other foodstuffs. Here, the influence of glucose and sodium bicarbonate on GBP stability was examined. As shown in Figure 5b, the GBP was relatively stable in the presence of glucose and sodium bicarbonate for 42 h. The effect of sodium bicarbonate on GBP was slightly lower than that of glucose, although neither showed a concentration-dependent relationship. Trace concentrations of metal ions may affect the stability of gardenia blue. Eight metal ions were employed to clarify the influence of different metal ions, and the GBP stability was compared (Figure 5c). Al3+, Fe2+, Fe3+, and Cu2+ had a much more significant influence on the stability of GBP than Na+, K+, Ca2+, or Mg2+ metal ions, with Al3+ and Fe3+ causing the most severe damage (Figure 5d). This effect may be due to the chelation reaction of Fe3+ with the amino acid residues of gardenia blue followed by precipitation, which disrupts the structure of gardenia blue pigment and causes discoloration. Furthermore, Fe2+ and Cu2+ may form complexes with gardenia blue pigment via coordination bonds, resulting in solution discoloration. Similarly, Al3+ and Fe3+ exhibit anthocyanin-like actions. Zhang et al. [31] reported that Al3+ and Fe3+ negatively influenced anthocyanins and diminished their stability.
Collectively, GBP produced by fermentation showed comparable physicochemical stability to that directly synthesized by genipin.
3.8. Molecular Formula Analysis
The secondary MS spectra of the purified GBP eluent are shown in Figure 6 and Figure S1. Through LC-MS analysis, four compounds were identified: compound 1, compound 2, compound 3, and compound 4. The results reveal that the molecular formulae of compound 1, compound 2, compound 3, and compound 4 are C6H13NO2, C17H24O10, C11H14O5, and C37H45N2O8, respectively. According to current experimental results combined with literature reports [14], we estimated that component 1, component 2, component 3, and component 4 were presumably leu, geniposide, genipin, and GBP, respectively. Because C37H45N2O8 is not listed in the Dictionary of Natural Products [32], we preliminarily speculate that the obtained GBP is a novel natural blue pigment.

Figure 6.
Secondary MS spectra of four compounds.
4. Conclusions
In this study, a novel bacterial strain, Leifsonia sp. ZF2019, was isolated from the larvae of a pest of Gardenia jasminoides Ellis fruits that can be used to prepare GBP from GYWP. Leifsonia sp. ZF2019 was identified by morphological and bioinformatic methods. The fermentation media and conditions were screened. Under optimal conditions, the conversion rate of geniposide reached 98%, and the yield and color scale of GBP were higher than those prepared by Aspergillus niger. GBP was purified by D4020 macroporous adsorbent resin, and the influence of pH, temperature, light, oxidant and reductant, conventional food additives, and metal ions on its stability was evaluated. GBP produced by Leifsonia sp. ZF2019 fermentation showed similar stability to that of GBP directly synthesized from pure genipin. LC-MS revealed that the molecular formula of GBP was C37H45N2O8. Collectively, our data suggest that preparing GBP by Leifsonia sp. ZF2019 fermentation represents an alternative method for blue pigment production with multiple advantages, including simple operation, mild conditions, suitable fermentation period, high yield, high conversion rate, and low cost.
Supplementary Materials
The following supporting information can be downloaded at: https://www.mdpi.com/article/10.3390/fermentation8100503/s1, Figure S1: Compound chromatograms of the purified GBP eluent; Table S1: Different resins affected the adsorption and resolution rates of GBP prepared by Leu fermentation.
Author Contributions
Software, C.W.; validation, Z.Z.; writing—original draft preparation, Y.H. and R.J.; writing—review and editing, Y.H. and R.J.; visualization, G.X.; supervision, G.X.; project administration, X.W.; funding acquisition, X.W. All authors have read and agreed to the published version of the manuscript.
Funding
The authors are grateful for the financial sponsorship of the National College Students’ Innovation and Entrepreneurship Training Program (No.202010341004).
Institutional Review Board Statement
Not applicable.
Informed Consent Statement
Not applicable.
Data Availability Statement
Not applicable.
Conflicts of Interest
The authors declare no conflict of interest.
References
- Oplatowska-Stachowiak, M.; Elliott, C.T. Food colors: Existing and emerging food safety concerns. Crit. Rev. Food Sci. Nutr. 2017, 57, 524–548. [Google Scholar] [CrossRef] [PubMed]
- Sigurdson, G.T.; Tang, P.; Giusti, M.M. Natural colorants: Food colorants from natural sources. Annu. Rev. Food Sci. Technol. 2017, 8, 261–280. [Google Scholar] [CrossRef] [PubMed]
- Sun, L.; Xin, F.; Alper, H.S. Bio-synthesis of food additives and colorants-a growing trend in future food. Biotechnol. Adv. 2021, 47, 107694. [Google Scholar] [CrossRef] [PubMed]
- Rodriguez-Amaya, D.B. Update on natural food pigments—A mini-review on carotenoids, anthocyanins, and betalains. Food Res. Int. 2019, 124, 200–205. [Google Scholar] [CrossRef]
- Olas, B.; Białecki, J.; Urbańska, K.; Bryś, M. The effects of natural and synthetic blue dyes on human health: A review of current knowledge and therapeutic perspectives. Adv. Nutr. Bethesda Md. 2021, 12, 2301–2311. [Google Scholar] [CrossRef]
- Paik, Y.; Lee, C.; Cho, M.; Hahn, T. Physical stability of the blue pigments formed from geniposide of gardenia fruits: Effects of pH, temperature, and light. J. Agric. Food Chem. 2001, 49, 430–432. [Google Scholar] [CrossRef]
- Newsome, A.G.; Culver, C.A.; van Breemen, R.B. Nature’s palette: The search for natural blue colorants. J. Agric. Food Chem. 2014, 62, 6498–6511. [Google Scholar] [CrossRef]
- Prado, J.M.; Veggi, P.C.; Náthia-Neves, G.; Meireles, M.A.A. Extraction methods for obtaining natural blue colorants. Curr. Anal. Chem. 2020, 16, 504–532. [Google Scholar] [CrossRef]
- Lee, S.-W.; Lim, J.-M.; Bhoo, S.-H.; Paik, Y.-S.; Hahn, T.-R. Colorimetric determination of amino acids using genipin from Gardenia jasminoides. Anal. Chim. Acta 2003, 480, 267–274. [Google Scholar] [CrossRef]
- He, Y.; Wang, C.X.; Jiao, R.H.; Ni, Q.X.; Wang, Y.; Gao, Q.X.; Zhang, Y.Z.; Xu, G.Z. Biochemical characterization of a novel glucose-tolerant GH3 β-glucosidase (Bgl1973) from Leifsonia sp. ZF2019. Appl. Microbiol. Biotechnol. 2022, 106, 5063–5079. [Google Scholar] [CrossRef]
- Neri-Numa, I.A.; Pessoa, M.G.; Paulino, B.N.; Pastore, G.M. Genipin: A natural blue pigment for food and health purposes. Trends Food Sci. Technol. 2017, 67, 271–279. [Google Scholar] [CrossRef]
- de Miranda Sabino, C.V.; Paula da Silva, B.J.; de Menezes, D.L.B.; Araújo da Silva, F.M.; de-Souza, T.P.; Henrique Ferreira Koolen, H.; de Lima Á, A.N.; Silva Lima, E. Physicochemical characterization, stability and cytotoxicity of a blue dye obtained from Genipap fruit (Genipa americana L.). Food Technol. Biotechnol. 2021, 59, 103–111. [Google Scholar] [CrossRef]
- Brauch, J.E.; Zapata-Porras, S.P.; Buchweitz, M.; Aschoff, J.K.; Carle, R. Jagua blue derived from Genipa americana L. fruit: A natural alternative to commonly used blue food colorants? Food Res. Int. 2016, 89 Pt 1, 391–398. [Google Scholar] [CrossRef] [PubMed]
- Hobbs, C.A.; Koyanagi, M.; Swartz, C.; Davis, J.; Maronpot, R.; Recio, L.; Hayashi, S.M. Genotoxicity evaluation of the naturally-derived food colorant, gardenia blue, and its precursor, genipin. Food Chem. Toxicol. 2018, 118, 695–708. [Google Scholar] [CrossRef] [PubMed]
- Li, K.D.; Yan, K.; Wang, Q.S.; Tian, J.S.; Xu, D.; Zhang, W.Y.; Cui, Y.L. Antidepressant-like effects of dietary gardenia blue pigment derived from genipin and tyrosine. Food Funct. 2019, 10, 4533–4545. [Google Scholar] [CrossRef]
- Chen, L.P.; Li, M.X.; Yang, Z.Q.; Tao, W.D.; Wang, P.; Tian, X.Y.; Li, X.L.; Wang, W.G. Gardenia jasminoides Ellis: Ethnopharmacology, phytochemistry, and pharmacological and industrial applications of an important traditional Chinese medicine. J. Ethnopharmacol. 2020, 257, 112829. [Google Scholar] [CrossRef]
- Li, N.; Fan, M.C.; Li, Y.; Qian, H.F.; Zhang, H.; Qi, X.G.; Wang, L. Stability assessment of crocetin and crocetin derivatives in gardenia yellow pigment and gardenia fruit pomace in presence of different cooking methods. Food Chem. 2020, 312, 126031. [Google Scholar] [CrossRef]
- Li, W.X.; Li, J.L.; Xu, Y.; Huang, Y.; Xu, S.Q.; Ou, Z.R.; Long, X.L.; Li, X.Y.; Liu, X.Y.; Xiao, Z.N.; et al. Expression of heat-resistant β-glucosidase in Escherichia coli and its application in the production of gardenia blue. Synth. Syst. Biotechnol. 2021, 6, 216–223. [Google Scholar] [CrossRef]
- Yang, Y.S.; Ding, Y.; Zhang, T. Biotransformation of geniposide into genipin by immobilized Trichoderma reesei and conformational study of genipin. Biomed. Res. Int. 2018, 2018, 2079195. [Google Scholar]
- Yang, D.; Zhou, M.; Wei, W.X.; Zhu, H.L.; Fan, X.W. Preparation of a genipin blue from egg protein and genipin. Nat. Prod. Res. 2012, 26, 765–769. [Google Scholar] [CrossRef]
- Hao, S.; Wang, J.; Li, S.; Shang, F.; Qin, Y.; Wu, T.T.; Bao, X.; Cao, Q.; Wang, C.T.; Sun, B.G. Preparation of gardenia red pigment and its antineoplastic activity in multiple tumor cells. Food Biosci. 2020, 35, 100582. [Google Scholar] [CrossRef]
- Basic Local Alignment Search Tool. Available online: http://www.ncbi.nlm.nih.gov/BLAST/ (accessed on 26 October 2020).
- Genus Leifsonia Taxonomy. Available online: https://www.bacterio.net/genus/leifsonia (accessed on 18 September 2020).
- Ouyang, Q.; Wang, P.; Huang, J.; Cai, J.B.; He, J.Y. Efficient enantioselective synthesis of (R)-[3,5-bis(trifluoromethyl)phenyl] ethanol by Leifsonia xyli CCTCC M 2010241 using isopropanol as co-substrate. J. Microbiol. Biotechnol. 2013, 23, 343–350. [Google Scholar] [CrossRef] [PubMed]
- Wang, P.; Cai, J.B.; Ouyang, Q.; He, J.Y.; Su, H.Z. Asymmetric biocatalytic reduction of 3,5-bis(trifluoromethyl) acetophenone to (1R)-[3,5-bis(trifluoromethyl)phenyl] ethanol using whole cells of newly isolated Leifsonia xyli HS0904. Appl Microbiol. Biotechnol. 2011, 90, 1897–1904. [Google Scholar] [CrossRef] [PubMed]
- Xu, M.M.; Sun, Q.; Su, J.; Wang, J.; Xu, C.; Zhang, T.; Sun, Q. Microbial transformation of geniposide in Gardenia jasminoides Ellis into genipin by Penicillium nigricans. Enzym. Microb. Technol. 2008, 42, 440–444. [Google Scholar] [CrossRef]
- Dai, Z.Y.; Aryal, U.K.; Shukla, A.; Qian, W.J.; Smith, R.D.; Magnuson, J.K.; Adney, W.S.; Beckham, G.T.; Brunecky, R.; Himmel, M.E.; et al. Impact of alg3 gene deletion on growth, development, pigment production, protein secretion, and functions of recombinant Trichoderma reesei cellobiohydrolases in Aspergillus niger. Fungal Genet. Biol. 2013, 61, 120–132. [Google Scholar] [CrossRef]
- Ray, A.C.; Eakin, R.E. Studies on the biosynthesis of aspergillin by Aspergillus niger. Appl. Microbiol. 1975, 30, 909–915. [Google Scholar] [CrossRef]
- Neri-Numa, I.A.; Angolini, C.F.F.; Bicas, J.L.; Ruiz, A.; Pastore, G.M. Iridoid blue-based pigments of Genipa americana L. (Rubiaceae) extract: Influence of pH and temperature on color stability and antioxidant capacity during in vitro simulated digestion. Food Chem. 2018, 263, 300–306. [Google Scholar] [CrossRef]
- Rehman, A.; Tong, Q.; Jafari, S.M.; Assadpour, E.; Shehzad, Q.; Aadil, R.M.; Iqbal, M.W.; Rashed, M.M.A.; Mushtaq, B.S.; Ashraf, W. Carotenoid-loaded nanocarriers: A comprehensive review. Adv. Colloid. Interface Sci. 2020, 275, 102048. [Google Scholar] [CrossRef]
- Zhang, M.; Lou, B.Y.; Zhang, Y.J.; Fu, H.X. Stability and antioxidant activity of anthocyanins from flowers of Rhododendron pulchrum sweet. Asian Agric. Res. 2018, 10, 88–92. [Google Scholar]
- Dictionary of Natural Products. Available online: https://dnp.chemnetbase.com/faces/chemical/ChemicalSearch.xhtml (accessed on 21 May 2021).
Publisher’s Note: MDPI stays neutral with regard to jurisdictional claims in published maps and institutional affiliations. |
© 2022 by the authors. Licensee MDPI, Basel, Switzerland. This article is an open access article distributed under the terms and conditions of the Creative Commons Attribution (CC BY) license (https://creativecommons.org/licenses/by/4.0/).